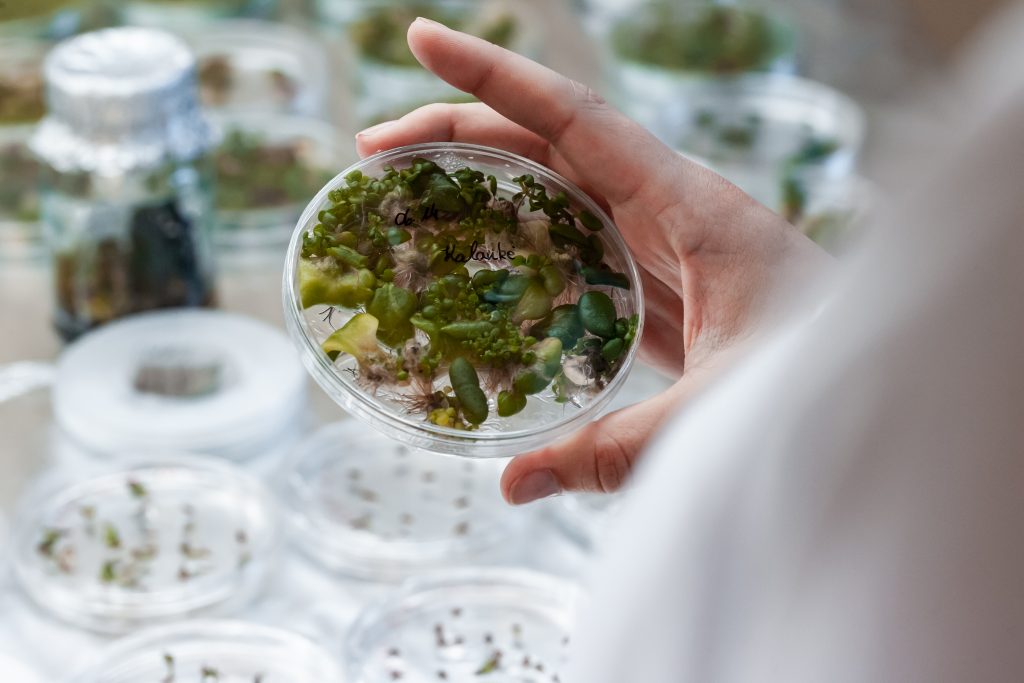

Dalykų studijos VDU ŽŪA – pažangi ir lanksti mokymosi galimybė

Dar visiškai neseniai atrodė savaime aišku, kad versle svarbiausia yra investuoti į priemones, didinančias darbuotojų darbo našumą. Šiuo metu pasaulis supranta, kad diegiant naujus verslo modelius bei technologijas dar svarbesnis veiksnys – darbuotojų išsilavinimas, naujos žinios bei kompetencijos.
Pastarąjį dešimtmetį vienas sparčiausiai modernėjančių sektorių pasaulyje ir Lietuvoje – žemės ūkis bei jį aptarnaujantys verslai. Todėl šiam sektoriui specialistus rengianti Vytauto Didžiojo universiteto Žemės ūkio akademija (VDU ŽŪA) nuolat ieško naujų, lanksčių, su tiesioginiu darbu suderinamų mokymo ir mokymosi formų, geriausiai atitinkančių darbo rinkos ir konkretaus žmogaus lūkesčius. Viena tokių naujovių – dalyko studijos, kurias galima pradėti jau šį semestrą.
Norinčiųjų praplėsti žinias laukiama jau šį semestrą
„Dalykų studijų forma ypač patogi asmenims, nenorintiems palikti savo darbo vietos bei jaučiantiems, kokių žinių jiems stinga. Universitetas sudaro puikias sąlygas mišriu ir nuotoliniu būdu „Moodle“ sistemoje bendrauti su dėstytojais, dalytis informacija su kitais studentais, pateikti atliktus darbus atsiskaitymams bei naudotis prieiga prie mokomosios medžiagos“, – nepraleisti progos praplėsti turimų žinių lauką ragina VDU ŽŪA kanclerė prof. Astrida Miceikienė.
Šį pavasario semestrą akademijoje siūlomas 12-os šiuolaikiškų studijų dalykų pasirinkimas: „Funkcionalusis maistas“, „Augalų mityba“, „Mikroekonomika“, „Makroekonomika“, „Verslo teisė“, „Finansų pagrindai“, „Verslo planavimas ir prognozavimas“, „Pasaulio ir regionų ekonomika“, „Akvakultūra“, „Miško atkūrimas ir įveisimas“, „Medynų formavimas ir kirtimai“, „Vandens biologija ir ekologija“.
VDU ŽŪA kanclerė atkreipia dėmesį, kad dalykų studijas tikslinga rinktis ne tik jau dirbantiesiems asmenims, kurie turi tikslą kelti kvalifikaciją ir įgyti naujų žinių bei gebėjimų, bet ir moksleiviams, kurie nori susipažinti su universitetu ir „pasimatuoti“ būsimą profesiją dar besimokydami mokykloje, studentams, dėl tam tikrų priežasčių nutraukusiems studijas ir norintiems į jas vėl sugrįžti, taip pat ieškantiesiems darbo ar keičiantiems jį ir norintiems įgyti papildomų žinių bei gebėjimų.
Sėkmingai baigus dalykų studijas įteikiama Akademinė pažyma, kuri pripažįstama visose Europos Sąjungos ir kitų šalių aukštosiose mokyklose, ir joje nurodyti išklausyti dalykai ir rezultatai yra įskaitomi.
Šiuolaikinis agrosektorius orientuotas į tarpdiscipliniškumą
„Agrosektorius – vienas sparčiausiai skaitmenizuojamų, robotizuojamų, besikeičiančių verslo segmentų ir vienas labiausiai pajutusių ketvirtosios pramonės revoliucijos poveikį – 2014 m. JAV pirmą kartą derlius buvo išaugintas lauke, į kurį nebuvo įžengęs žmogus – viską atliko automatizuotos sistemos. Tad akivaizdu, jog norint sėkmingai plėtoti agroverslą, vis didesnę svarbą įgyja kompleksinės žinios. Todėl siekiant efektyviai spręsti problemas, dažnai kylančias disciplinų sandūroje, darbuotojo tobulinimas turi vykti kompleksiškai, sujungiant tarpdisciplinines žinias ir išteklius tokiose aktualiose srityse kaip bioekonomika, biotechnologijos, dirbtinis intelektas, agroinovacijos, technologijų teisė, klimato kaita, darnus vystymasis ir daugelyje kitų“, – įsitikinusi A. Miceikienė.
VDU ŽŪA kanclerės teigimu, žemės ūkis neatsitiktinai laikomas vienu perspektyviausių sektorių. Šiuo metu vienas iš devynių pasaulio gyventojų stokoja maisto, todėl jo poreikis ateityje augs tik dar labiau, vadinasi, ir žemės ūkio specialistų reikės vis daugiau. Be to, planetos ištekliai yra riboti, todėl nuolat turi būti kuriamos inovacijos, padedančios juos tausoti. Šių inovacijų plėtojimui taip pat reikės aukštos kvalifikacijos specialistų.
„Maža to, agrosektorius yra labiausiai skaitmenizuotas, palyginti su kitais sektoriais. Pavyzdžiui, prognozuojama, jog per ateinančius 10 metų robotai bus kiekvieno modernaus ūkio arba modernios žemės ūkio įmonės dalimi. Dronų naudojimas agrosektoriuje jau dabar yra plačiai paplitęs. Inžinieriai, agronomai, netgi tokie specialistai kaip laukinės gamtos atkūrėjai (angl. rewilder) yra tie, kurie turėdami skaitmenizacijos, informatikos, žemės ūkio technologijų žinių kurs ateities žemės ūkį“, – prognozuoja VDU Žemės ūkio akademijos kanclerė, pastebėdama, kad šiuolaikinio žmogaus studijos neturi apsiriboti viena sritimi arba specializacija.
Darbdaviai ragina nepaliauti mokytis
Būtinybę darbuotojams rengtis naujiems iššūkiams ir technologijų plėtrai šiandien akcentuoja praktiškai visų agrosektoriaus sričių darbdaviai.
„Šiandien neįmanoma įsivaizduoti nė vienoje srityje dirbančio specialisto, kuris nuolat nesitobulintų, nes priešingu atveju žmogus beregint ima atsilikti nuo naujausių mokslo ir technologijų tendencijų. Šiuolaikinis agrosektorius vystosi neįtikėtinai sparčiai ir naujausioms žinioms yra ypač imlus, todėl nuolat mokytis turi ir ūkininkai, ir jų konsultantai. Mūsų įmonės interesas bendradarbiauti su VDU Žemės ūkio akademija žinių sklaidos srityje yra labai didelis. Ir šis bendradarbiavimas vyksta labai aktyviai. Mes kviečiame dėstytojus ir studentus į seminarus, kuriuos veda iš užsienio technikos gamyklų atvykę specialistai, akademijos ekspertai veda mokymus mūsų darbuotojams bei klientams, VDU ŽŪA Mokomajam ūkiui suteikiame naujausią savo techniką bei drauge su akademijos mokslininkais atliekame eksperimentus, kurių rezultatais vėliau galėtų pasinaudotis visi šalies ūkininkai“, – mokslo ir verslo bendradarbiavimo svarbą komentuoja UAB „Dojus agro“ Lietuvos filialo direktorė Diana Tatarūnaitė Zubenienė, pastebėdama, kad šioje įmonėje yra darbuotojų, kurie nėra baigę žemės ūkio krypties studijų. Šie darbuotojai geri praktikai, bet stokoja teorinių pagrindų.
Pradėti bakalauro studijas ir sėsti į pirmakursio suolą tokiems žmonėms būtų sudėtinga, todėl dalykų studijos yra labai aktualios. „Vienareikšmiai raginsime savo darbuotojus pasinaudoti šia galimybe ir suteiksime tam visas sąlygas“, – teigia pašnekovė.
Prašymai priimami pavasario semestrui iki vasario 15 d. Išsami informacija el. paštu: debora.augutyte@vdu.lt.